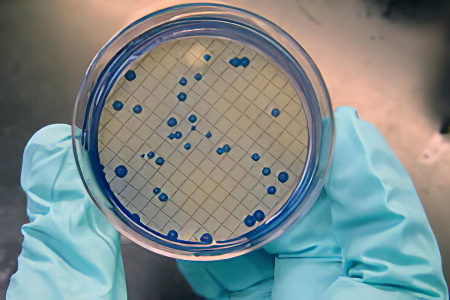
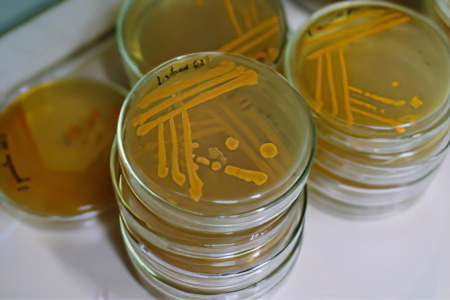
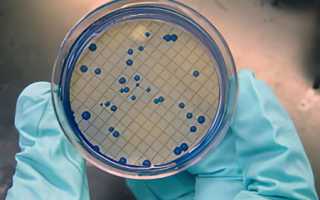

Что показывает копрограмма кала?
В процессе копрологического анализа рассматриваются следующие категории характеристик кала:
- Макроскопические – общий суточный объем, форма, консистенция, цвет и запах фекалий, а также наличие посторонних включений (остатки непереваренной пищи, слизь, кровь, гной, паразиты и их цисты);
- Химические – уровень кислотности и щелочности испражнений, наличие скрытой крови, желчных пигментов и растворимых белков;
- Микроскопические – присутствие детрита, крахмала, жирных кислот, соединительной ткани, лейкоцитов, эритроцитов, грибков и других компонентов.
На основе этих показателей врач может оценить состояние желудочно-кишечного тракта пациента. Это позволяет выяснить, насколько эффективно происходит переваривание пищи, правильно ли она движется по кишечнику и в достаточном ли объеме усваиваются питательные вещества. Кроме того, анализ кала может помочь заподозрить воспалительные или онкологические процессы в пищеварительной системе, выявить нарушения в работе поджелудочной железы, печени, желудка и кишечника, а также наличие камней в желчном пузыре, дивертикулов, геморроя, варикозного расширения вен пищевода и других заболеваний.
Врачи подчеркивают важность копрограммы как одного из основных методов диагностики заболеваний желудочно-кишечного тракта. Нормальные результаты анализа включают отсутствие крови, слизей и паразитов, а также наличие определенного количества клетчатки и жиров. Отклонения от этих норм могут указывать на различные патологии, такие как воспалительные процессы, инфекции или нарушения пищеварения. Специалисты отмечают, что правильная интерпретация результатов требует учета клинической картины пациента и его анамнеза. Поэтому важно, чтобы пациенты не занимались самодиагностикой, а обращались к врачам для получения квалифицированной помощи и рекомендаций. Врачи настоятельно рекомендуют проходить копрограмму регулярно, особенно при наличии симптомов, таких как боли в животе, изменения стула или потеря веса.

Показания к проведению копрологического исследования
Обратиться к врачу для получения направления на анализ кала необходимо в следующих случаях:
- Боли в животе. Это могут быть опоясывающие боли, дискомфорт в верхней или нижней части живота, а также в правом или левом подреберье. Даже легкие неприятные ощущения в области печени, желудка, кишечника или поджелудочной железы должны стать поводом для обследования, особенно если они возникают без видимой причины и часто повторяются.
- Симптомы, такие как отрыжка, изжога, тошнота, рвота и необычный привкус во рту.
- Вздутие живота, метеоризм, диарея или запоры.
- Изменения в внешнем виде, запахе или цвете стула, ненормальный объем испражнений или наличие подозрительных включений.
- Наличие крови, гноя или слизи на нижнем белье в области анального отверстия, болезненность, зуд или ощущение инородного тела в прямой кишке.
- Необходимость контроля состояния органов пищеварения в процессе лечения, перед диагностическими процедурами, хирургическими вмешательствами или в профилактических целях (рекомендуется раз в год).
- Подозрения на отравление, новообразования или паразитарные инфекции.
- Аллергические реакции или непереносимость определенных продуктов.
- Резкое и значительное снижение веса без видимых причин.
- Копрограмма для младенцев назначается при частой и сильной отрыжке, коликах, диарее, запорах или трудностях с введением нового прикорма.
| Показатель | Норма | Отклонение и возможные причины |
|---|---|---|
| Цвет кала | Коричневый | Светлый (желтый, белый): нарушение оттока желчи (обтурационная желтуха, гепатит), прием активированного угля, мальабсорбция. Черный (дегтеобразный): кровотечение в верхних отделах ЖКТ. Зеленый: ускоренный пассаж пищи по кишечнику, прием некоторых лекарств. |
| Консистенция кала | Формированный | Жидкий (диарея): инфекционные заболевания, воспалительные заболевания кишечника, непереносимость пищи, дисбактериоз. Твердый (запор): недостаток жидкости, гиподинамия, заболевания толстой кишки. |
| Реакция pH | Слабощелочная (7,0-7,6) | Кислая: повышенная кислотность желудочного сока, запор. Щелочная: брожение в кишечнике, дисбактериоз. |
| Слизь | Отсутствует | Присутствие: воспалительные процессы в кишечнике (энтерит, колит), паразитарные инвазии. |
| Кровь | Отсутствует | Присутствие: кровотечения в ЖКТ (язвенная болезнь, рак толстой кишки, геморрой). Скрытая кровь: небольшие кровотечения, эрозии. |
| Лейкоциты | Отсутствуют или единичные | Повышенное количество: воспалительные процессы в кишечнике, инфекции. |
| Мышечные волокна | Непереваренные мышечные волокна в небольшом количестве | Большое количество: недостаточность функции поджелудочной железы, нарушение пищеварения. |
| Нейтральный жир | Отсутствует или в небольшом количестве | Большое количество: нарушение функции поджелудочной железы, мальабсорбция. |
| Жирные кислоты | Отсутствуют или в небольшом количестве | Большое количество: нарушение всасывания жиров. |
| Крахмал | Отсутствует или в небольшом количестве | Большое количество: нарушение функции поджелудочной железы, ускоренный пассаж пищи. |
| Йодофильная флора | В небольшом количестве | Большое количество: дисбактериоз. |
Как сдавать кал: подготовка и правила сбора
Важно тщательно следовать рекомендациям врача при подготовке к исследованию, так как это напрямую влияет на точность интерпретации результатов копрограммы и, соответственно, на правильность диагноза.
Рассмотрим, как правильно сдать кал на анализ:
- На этапе получения направления сообщите врачу обо всех лекарствах, которые вы принимали в последние недели или принимаете в данный момент, а также о любых диагностических процедурах, проведенных накануне. Рентгеноконтрастные вещества могут изменить состав кала, а инвазивные процедуры, такие как колоноскопия, могут вызвать внутренние повреждения и кровотечения в кишечнике. К нежелательным препаратам относятся антибиотики, противоглистные и слабительные средства, активированный уголь, препараты железа и висмута, ректальные суппозитории и другие медикаменты, поэтому лучше заранее уведомить врача о всех них.
- За 3-5 дней до копрологического исследования измените рацион, исключив блюда и продукты, которые могут окрасить кал в необычные цвета (например, свеклу, красные и черные ягоды, морковь, шпинат). Возможно, врач порекомендует специальную диету, которая поможет прояснить проблемы с работой определенных органов пищеварения. Например, может быть предложено несколько дней питаться в основном крупами, молочными продуктами, сырыми овощами и фруктами, белковой пищей и т.д.
- Непосредственно перед сбором кала опорожните мочевой пузырь, так как в противном случае во время дефекации есть риск попадания мочи в образец, что недопустимо. Затем проведите интимный туалет, тщательно вымыв область промежности с мылом, уделяя особое внимание перианальной зоне, после чего сполоснитесь и высушитесь.
- Собирать кал для анализа не рекомендуется непосредственно из унитаза, так как там могут находиться патогенные бактерии или остатки агрессивных моющих средств. Лучше подготовить удобную емкость (старую кастрюлю или миску), тщательно вымыть её и обдать кипятком, а затем произвести дефекацию в неё. Для детей копрограмма берется из чистого горшка, а у грудничков – с пеленки или клеенки; не стоит собирать образец с памперса, так как в его наполнителе могут быть химические примеси, которые исказят результаты исследования.
- Дефекация должна происходить естественным образом, без стимуляции кишечника препаратами или клизмами. Полученные таким образом испражнения не подходят для анализа. После завершения процесса сразу соберите образцы из разных частей фекалий, особенно с участков, отличающихся цветом и консистенцией или имеющих подозрительные включения. Для сбора кала лучше всего использовать специальный пластиковый контейнер с ложечкой, который можно приобрести в аптеке. Для копрологического исследования потребуется около 20 г материала.
- Образец кала необходимо доставить в лабораторию в течение максимум 2 часов после сбора. Крышка контейнера должна быть плотно закрыта, чтобы избежать воздействия открытого воздуха на состав кала. Допускается предварительное хранение материала в холодильнике при температуре не выше -5 °C и не дольше 12 часов. Однако чем быстрее вы доставите кал на исследование, тем более точными будут результаты.
Копрограмма — это важный лабораторный анализ, который помогает оценить состояние пищеварительной системы и выявить различные заболевания. Многие люди, проходя это исследование, интересуются, что именно говорят результаты. Нормы копрограммы включают в себя такие параметры, как цвет, консистенция, запах, наличие непереваренной пищи, а также микроскопические элементы, такие как слизь, жиры и клетки.
Расшифровка результатов может указать на наличие инфекций, воспалительных процессов или нарушений в работе органов пищеварения. Например, светлый цвет кала может свидетельствовать о проблемах с печенью или желчными путями, а наличие крови — о возможных язвах или опухолях. Важно помнить, что интерпретацию результатов должен проводить квалифицированный специалист, который учтет все факторы, включая анамнез и клинические проявления. Таким образом, копрограмма становится важным инструментом для диагностики и мониторинга здоровья.

Ответы на часто задаваемые вопросы о копрограмме
-
Какова стоимость анализа кала на копрограмму? Цены варьируются в зависимости от региона и политики частных медицинских учреждений. В среднем, копрологическое исследование в качественном медицинском центре стоит от 350 до 1000 рублей. В государственных поликлиниках анализ можно сдать бесплатно при наличии жалоб и полиса обязательного медицинского страхования.
-
Как долго ждать результаты? Частные медицинские учреждения обычно быстро обрабатывают анализы и предоставляют результаты копрограммы на следующий день. Лаборатории при поликлиниках передают готовые результаты в течение 1-3 дней врачу, к которому обратился пациент, чаще всего участковому терапевту или педиатру. Таким образом, вы сможете узнать результаты на следующем приеме.
-
Можно ли заморозить и сдать на анализ кал, собранный вчера? Да, это допустимо. У каждого человека свои биоритмы: некоторые опорожняют кишечник вечером, а утром не испытывают необходимости. С маленькими детьми, особенно грудничками, собрать свежий кал для анализа может быть сложно, поэтому можно использовать образец, собранный ранее.
-
Нужно ли сдавать кал в специальном контейнере? Это не обязательно, но контейнер соответствует всем гигиеническим стандартам, удобен в использовании и стоит недорого. Частные клиники обычно предоставляют контейнеры вместе с направлением на копрограмму, и их стоимость включена в общую цену услуги. В государственной лаборатории можно сдать кал в любой подходящей таре, например, в маленькой герметичной баночке из пластика или стекла, но нужно подтвердить, что она была тщательно вымыта.
-
Какой объем кала необходим для копрограммы? Достаточно объема, примерно равного одной чайной ложке. Лучше собирать образец из разных частей каловых масс для более точной оценки состава и свойств испражнений. Если вы используете специальный контейнер с ложечкой, рекомендуется взять 3-5 порций из разных участков фекалий.
-
Можно ли делать копрограмму во время менструации? Это нежелательно. Лучше дождаться окончания менструального кровотечения, чтобы избежать попадания крови в образец и искажения результатов анализа. Если есть неотложные показания и состояние здоровья требует срочного анализа, можно сдать кал, но во время дефекации следует использовать гигиенический тампон или стерильную вату для надежной защиты.
-
Действительно ли перед копрограммой нужно избегать анального секса? Да, это правда. Однако не все врачи предупреждают пациентов о необходимости временного воздержания от таких практик из-за деликатности темы. Во время анального секса могут возникать микроскопические повреждения прямой кишки, что может привести к ложноположительным результатам анализа на скрытую кровь.
-
Всегда ли копрограмма достаточна для точной диагностики? Нет, это базовый тест, который позволяет заподозрить наличие проблемы и наметить дальнейшие шаги для обследования. Часто по итогам копрологии пациента направляют на дополнительные исследования, такие как бактериологический анализ кала, УЗИ органов брюшной полости, рентгеноконтрастная томография, колоноскопия, ректороманоскопия и другие диагностические процедуры.
Норма копрограммы кала в таблице

Макроскопические параметры
Химические параметры
Микроскопические параметры
Расшифровка копрограммы у детей и взрослых
Давайте проанализируем каждый из показателей таблицы и выделим возможные причины отклонений от нормы. Однако стоит отметить, что эта задача требует квалифицированного специалиста. Результаты копрологического исследования, без учета симптомов, анамнеза и данных других анализов, имеют ограниченную информативность и не могут служить основанием для окончательной диагностики.
Суточный объём
Суточный объём каловых масс изменяется в зависимости от рациона. При увеличении доли сырой растительной пищи он возрастает, а при преобладании белковых продуктов (мясо, рыба, яйца) — снижается. Тем не менее, количество кала, выделяемое человеком за сутки, должно оставаться в пределах норм, указанных в таблице.
Причины увеличения объёма кала:
- Энтероколит;
- Холецистит;
- Панкреатит;
- Бродильная или гнилостная диспепсия;
- Увеличение перистальтики кишечника;
- Синдром раздражённого кишечника.
Причины уменьшения объёма кала:
- Недостаточное питание;
- Запоры.
Консистенция
Консистенция стула в значительной степени зависит от содержания воды в нем. В норме кал должен иметь четкую форму и быть цилиндрическим как у детей, так и у взрослых. Это возможно, если 70-75% его объема составляет жидкость. Исключение составляют грудные дети: при грудном вскармливании их кал будет кашеобразным, а при искусственном питании – иметь консистенцию, напоминающую замазку, что является нормальным явлением.
Причины ненормальной консистенции кала:
- Очень твердый («овечий») – может указывать на запор, стеноз толстого кишечника или спазмы его стенок.
- Жидкий – часто связан с диареей, синдромом раздраженного кишечника или повышенной перистальтикой.
- Пенистый – может свидетельствовать о бродильной диспепсии, энтероколите, дизентерии или сальмонеллезе.
- Мазевидный – обычно указывает на панкреатит, холецистит или желчнокаменную болезнь.
Цвет
Испражнения здорового взрослого человека и ребенка старше года имеют коричневый оттенок благодаря желчному пигменту стеркобилину.
У детей, питающихся исключительно грудным молоком, кал светло-желтый, золотисто-желтый или зеленовато-желтый. У малышей на искусственном вскармливании цвет фекалий может быть темно-желтым, темно-оранжевым или желто-коричневым.
Цвет кала у взрослых зависит от продуктов питания и некоторых лекарств. Поэтому правильная интерпретация копрограммы может быть затруднена, если пациент не соблюдает рекомендации по подготовке к исследованию.
Аномальный цвет кала – возможные причины:
- Черный, дегтеобразный – может указывать на кровотечение из верхних отделов желудочно-кишечного тракта, варикоз вен пищевода, язву или рак желудка.
- Темно-коричневый – часто свидетельствует о запоре, избытке белковой пищи или нарушениях в ее переваривании, колите, диспепсии.
- Светло-коричневый – может быть вызван избытком растительной пищи, синдромом раздраженного кишечника или усиленной перистальтикой.
- Красно-коричневый – может указывать на язвенный колит.
- Светло-желтый – может быть признаком панкреатита.
- Серо-белый – может свидетельствовать о гепатите, циррозе печени или закупорке желчных путей.
Запах
Запах фекалий обусловлен наличием различных веществ, таких как метан, фенол, скатол, индол и сероводород. Их пропорции зависят от рациона питания. При анализе копрограммы у детей и взрослых нормой считается привычный, не резкий запах. У малышей до шести месяцев наблюдается кисловатый аромат, что связано с питанием материнским молоком или искусственными смесями. При искусственном вскармливании запах может быть более выраженным.
Причины ненормального запаха кала:
- Кислый – бродильная диспепсия;
- Гнилостный – энтероколит, нарушения в работе желудка, гнилостная диспепсия;
- Зловонный – панкреатит, холецистит, желчнокаменная болезнь, закупорка желчных путей;
- Запах прогорклого масла – гепатит, жировой гепатоз, цирроз печени.
Непереваренная пища
В норме в кале здорового человека не должно быть частиц непереваренной пищи. Если такие частицы присутствуют, особенно в большом количестве, это может указывать на серьезные проблемы с работой желудка, поджелудочной железы или печени.
Слизь
У младенцев в стуле может быть небольшое количество слизи, но она должна быть прозрачной и едва заметной. У детей старшего возраста и взрослых наличие слизи в кале считается отклонением от нормы и может указывать на проблемы со здоровьем.
Причины появления слизи в кале:
- Геморрой
- Полипы или дивертикулез кишечника
- Муковисцидоз
- Целиакия
- Синдром мальабсорбции
- Нехватка лактазы
- Острые кишечные инфекции
- Паразитарные инфекции
- Синдром раздраженного кишечника
Кровь
Наличие крови в кале у взрослых и детей при анализе копрограммы является тревожным сигналом, указывающим на возможные серьезные заболевания органов желудочно-кишечного тракта. Важно обратить внимание на характер крови, её количество и время появления, так как это может помочь в установлении причин проблемы.
Кровь в кале – возможные причины:
- Ярко-красная кровь на туалетной бумаге или на поверхности фекалий может свидетельствовать о геморрое или трещинах в анальной области.
- Прожилки крови в кале могут указывать на язвенный колит, болезнь Крона или рак толстого кишечника.
- Кровь в жидком стуле часто связана с дизентерией и другими кишечными инфекциями.
- Слизь с кровью может быть признаком парапроктита, язвенного колита, полипоза или дивертикулеза.
- Пятна крови на нижнем белье могут свидетельствовать о раке прямой кишки.
- Обильное кровотечение из заднего прохода может быть связано с ишемическим колитом или повреждением геморроидального узла.
Гной
Наличие гнойных примесей в кале у младенцев, детей старшего возраста и взрослых — это серьезное отклонение от нормы копрограммы. Чаще всего оно указывает на воспалительный процесс в органах желудочно-кишечного тракта. В таких случаях необходимо провести дополнительное обследование для выявления причины и точного местоположения воспаления, а также определения конкретных возбудителей.
Паразиты, цисты
В кале здорового взрослого человека или ребёнка не должны быть обнаружены простейшие, глисты и их яйца. Если при анализе кала они выявляются, необходимо провести специальную антипаразитарную терапию, назначенную врачом. Учтите, что большинство противоглистных препаратов токсичны, поэтому выбор лекарства должен учитывать все особенности здоровья пациента, особенно если это касается маленького ребёнка.
Кислотность, pH
У новорожденных детей реакция стула обычно кислая или слабокислая. Это связано с тем, что их питание состоит преимущественно из материнского молока или искусственных смесей. У детей старшего возраста и взрослых наблюдается нейтральная реакция кала. Изменение этого показателя в кислую сторону может быть вызвано избытком углеводов в рационе или их недостаточным перевариванием. Щелочная реакция, в свою очередь, может возникнуть из-за высокого содержания белков.
Причины нарушений кислотности кала:
- Щелочная (pH 8,0-8,5) – панкреатит, колит, запоры;
- Слабощелочная (pH 7,5-8,0) – дисфункция тонкого кишечника;
- Сильнощелочная (pH выше 8,5) – гнилостная диспепсия;
- Сильнокислая (pH ниже 5,5) – бродильная диспепсия.
Скрытая кровь
Реакция кала на скрытую кровь должна быть отрицательной. Положительный результат может указывать на эрозивный гастрит, язву желудка, язвенный колит, дивертикулез, геморрой или злокачественные опухоли в органах желудочно-кишечного тракта. Возможные диагнозы разнообразны. Поэтому положительный результат анализа кала на скрытую кровь при интерпретации копрограммы требует более детального обследования пациента.
Билирубин
В нормальных условиях кишечная микрофлора обрабатывает желчный пигмент билирубин, превращая его в стеркобилин. У младенцев до 6 месяцев организм только начинает заселяться бактериями, и формируется здоровый баланс. Поэтому небольшое количество билирубина в стуле грудных детей считается нормальным, в то время как у взрослых это является серьезным отклонением.
Билирубин в стуле – возможные причины:
- Синдром раздраженного кишечника;
- Увеличенная перистальтика и ускоренное выведение каловых масс;
- Дисбактериоз кишечника, вызванный длительным применением антибиотиков.
Стеркобилин
Это вещество образуется в результате переработки билирубина кишечными микробами и придаёт испражнениям коричневый оттенок. У взрослого человека в сутки выделяется от 75 до 350 мг стеркобилина, у младенцев этот показатель может быть ниже. Однако у взрослых уровень стеркобилина должен оставаться в пределах нормы.
Причины повышения стеркобилина в кале:
- Увеличенная секреция желчи;
- Гемолитическая анемия.
Причины понижения стеркобилина в кале:
- Панкреатит;
- Гепатит;
- Желчнокаменная болезнь;
- Холангит;
- Механическая желтуха.
Растворимый белок
При анализе копрограммы растворимый белок в кале должен быть отрицательным как у младенцев, так и у детей старшего возраста и взрослых. Положительный результат может указывать на проблемы, такие как гнилостная диспепсия или воспалительные процессы в органах желудочно-кишечного тракта, включая гастрит, энтероколит и панкреатит.
Детрит
Детрит — это совокупность мелких частиц переваренной пищи, клеток эпителия кишечника, бактерий, продуктов их жизнедеятельности, солей, токсинов и других элементов, которые должны регулярно выводиться из организма. Специалисты считают, что детрит является индикатором эффективности пищеварительного процесса: чем больше этого вещества в кале, тем лучше.
Аммиак
У здоровых младенцев копрограмма обычно показывает отсутствие аммиака в кале. У детей старшего возраста и взрослых это вещество может присутствовать в небольших количествах (20-40 ммоль/кг), что считается нормой. Значительное повышение уровня аммиака в кале может указывать на нарушения в переваривании белков, а также на наличие гнилостной диспепсии или колита.
Крахмал
Этот сложный углевод у здоровых людей полностью перерабатывается в желудочно-кишечном тракте. Поэтому крахмал не должен присутствовать в кале ни у детей, ни у взрослых. Если результаты копрограммы показывают иное, это может указывать на панкреатит, гастрит с пониженной кислотностью или бродильную диспепсию.
Нейтральные жиры
Триглицериды — ключевой источник энергии, и в норме они полностью усваиваются, не оставляя следов в кале. У младенцев допускается небольшое количество нейтральных жиров в испражнениях, так как ферментная активность их пищеварительной системы еще не достигла необходимого уровня. Однако это временное явление. Если триглицериды обнаруживаются в анализах кала у взрослого или ребенка старше одного года, это может указывать на проблемы с поджелудочной железой, печенью, желчным пузырем или тонким кишечником.
Жирные кислоты
Эти соединения образуются при переработке нейтральных жиров и могут встречаться в продуктах питания. У здорового человека жирные кислоты полностью усваиваются организмом, поэтому их не должно быть в кале. Значительные отклонения от нормы могут указывать на панкреатит или заболевания печени и желчных путей. У младенцев жирные кислоты могут обнаруживаться в кале в небольших количествах из-за недостаточной активности ферментов поджелудочной железы.
Мыла
В результате переработки жиров в желудочно-кишечном тракте образуются мыльные соединения, которые можно обнаружить в кале людей всех возрастов, включая младенцев. Это считается нормой для копрограммы. Если в результатах анализа указано, что мыла в испражнениях нет, это может свидетельствовать о проблемах с поджелудочной железой или печенью, а также о наличии камней в желчном пузыре.
Перевариваемая растительная клетчатка
Растительные волокна можно разделить на две группы: перевариваемые и неперевариваемые организмом. К неперевариваемым относятся жесткие оболочки плодов, скорлупа орехов и твердые жилки растений. Клетчатка, которую организм может усвоить, не должна присутствовать в каловых массах. Если она обнаруживается в них, это может свидетельствовать о том, что пищеварительная система не справляется с нагрузкой или человек употребляет слишком много сырых овощей и фруктов.
Волокна мышц и соединительной ткани
Частицы мышечных волокон и соединительных тканей образуются в результате переваривания белковой пищи, такой как мясо, рыба, птица и морепродукты. Согласно стандартам анализа копрограммы, у детей и взрослых в кале может встречаться небольшое количество таких элементов. Их минимальное количество является положительным признаком, указывающим на эффективную работу ферментной системы пищеварения.
Лейкоциты
Иммунные клетки в кале указывают на воспалительный процесс в желудочно-кишечном тракте. Небольшое количество таких клеток в поле зрения при копрологическом анализе считается нормой. Однако высокое содержание лейкоцитов в кале вызывает беспокойство и требует дополнительного обследования.
Дрожжевые грибки
Микроорганизмы данного типа являются условно-патогенными и обычно присутствуют в кишечнике здоровых людей всех возрастов. Однако обнаружение дрожжевых грибков в кале свидетельствует о значительном увеличении их количества, что указывает на дисбактериоз. Эта ситуация часто возникает, например, после курса антибиотиков. Для решения проблемы можно использовать препараты, содержащие живые бифидобактерии и лактобациллы.
Патогенная флора
В эту группу входят патогенные микроорганизмы, вызывающие дизентерию, сальмонеллез и другие кишечные заболевания. Результаты копрограммы должны показывать полное отсутствие этих бактерий в кале. Если они будут обнаружены, пациенту потребуется курс антибактериальной терапии, назначенный врачом.
Берегите себя и оставайтесь здоровыми!
Диетолог-нутрицолог Ульяна Любимова из КДЦ «Диетологи России» поделится рекомендациями по правильной сдаче копрограммы, ее расшифровке и самодиагностике состояния пищеварительной системы:
Вопрос-ответ
Что в копрограмме указывает на воспаление в кишечнике?
Большое количество лейкоцитов в кале свидетельствует о воспалении в различных отделах кишечника, вызванном развитием инфекции или другими причинами. Эритроциты – красные клетки крови.
Что в копрограмме указывает на хронический панкреатит?
Копрограмма (общий анализ кала) позволяет оценить качество усвоения организмом питательных веществ. При хроническом панкреатите количество жиров в кале повышается, жир и белки могут встречаться в непереваренном виде.
Советы
СОВЕТ №1
Перед сдачей копрограммы убедитесь, что вы соблюдаете все рекомендации врача. Это может включать в себя временное исключение определенных продуктов из рациона, таких как мясо или молочные изделия, а также отказ от приема некоторых лекарств, которые могут повлиять на результаты анализа.
СОВЕТ №2
Соблюдайте правила сбора образца. Для копрограммы необходимо использовать чистую и сухую емкость. Избегайте загрязнения образца мочой или водой, так как это может исказить результаты анализа.
СОВЕТ №3
Обратите внимание на сроки доставки образца в лабораторию. Чем быстрее вы доставите образец, тем точнее будут результаты. Обычно рекомендуется сдать образец в течение 1-2 часов после сбора.
СОВЕТ №4
Не забывайте, что результаты копрограммы следует интерпретировать в контексте других клинических данных. Обсудите результаты с врачом, чтобы получить полное представление о состоянии вашего здоровья и необходимых дальнейших действиях.